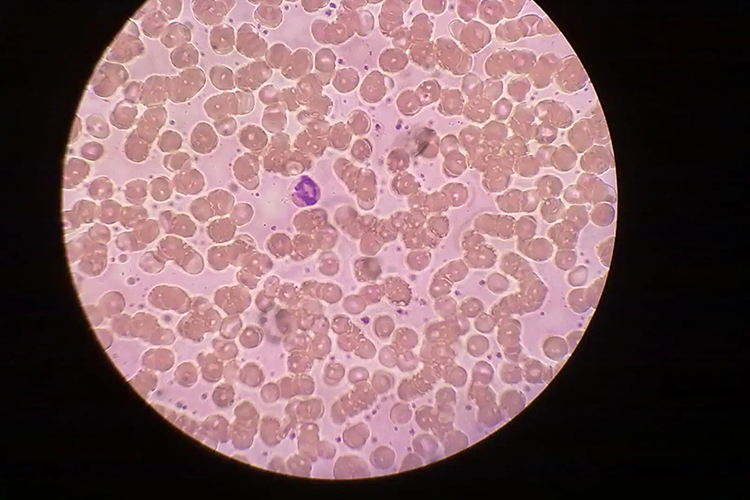
尿红细胞形态图 尿红细胞形态图

概述
尿液中红细胞正常形态为双凹圆盘状,中央较薄,边缘较厚,尿红细胞形态检查可判定血尿来源。
形态
正常人离心尿中红细胞仅为0-2个高倍视野(HDF),正常红细胞平均直径7.2μm,形态呈双凹圆盘状,中央较薄,边缘较厚,染色后呈淡红色略带紫色,中央部分较淡染,无核。当出现血尿时,尿液中的红细胞形态可因来源不同发生相应变化。
临床意义
尿液中红细胞≥3个/HPF考虑为血尿,通过仪器测定尿红细胞形态对判断血尿来源有一定意义。若尿中红细胞形态以变形红细胞为主,属肾小球性血尿。若红细胞形态基本正常、均一,则为非肾小球性血尿。若红细胞形态严重变形呈芽孢、环状、穿孔等改变,其数目≥30%以上考虑为肾性血尿。如以均一型红细胞为主,变形红细胞数目<10%,应考虑为非肾性血尿。
参考文献
[1]中华医学会儿科学分会.儿科肾脏系统疾病诊疗规范.第1版[M].北京.人民卫生出版社.2016.1-4.
[2]王学锋,管洪在.临床血液学检验.第3版[M].北京.中国医药科技出版社.2019.53.
展开






